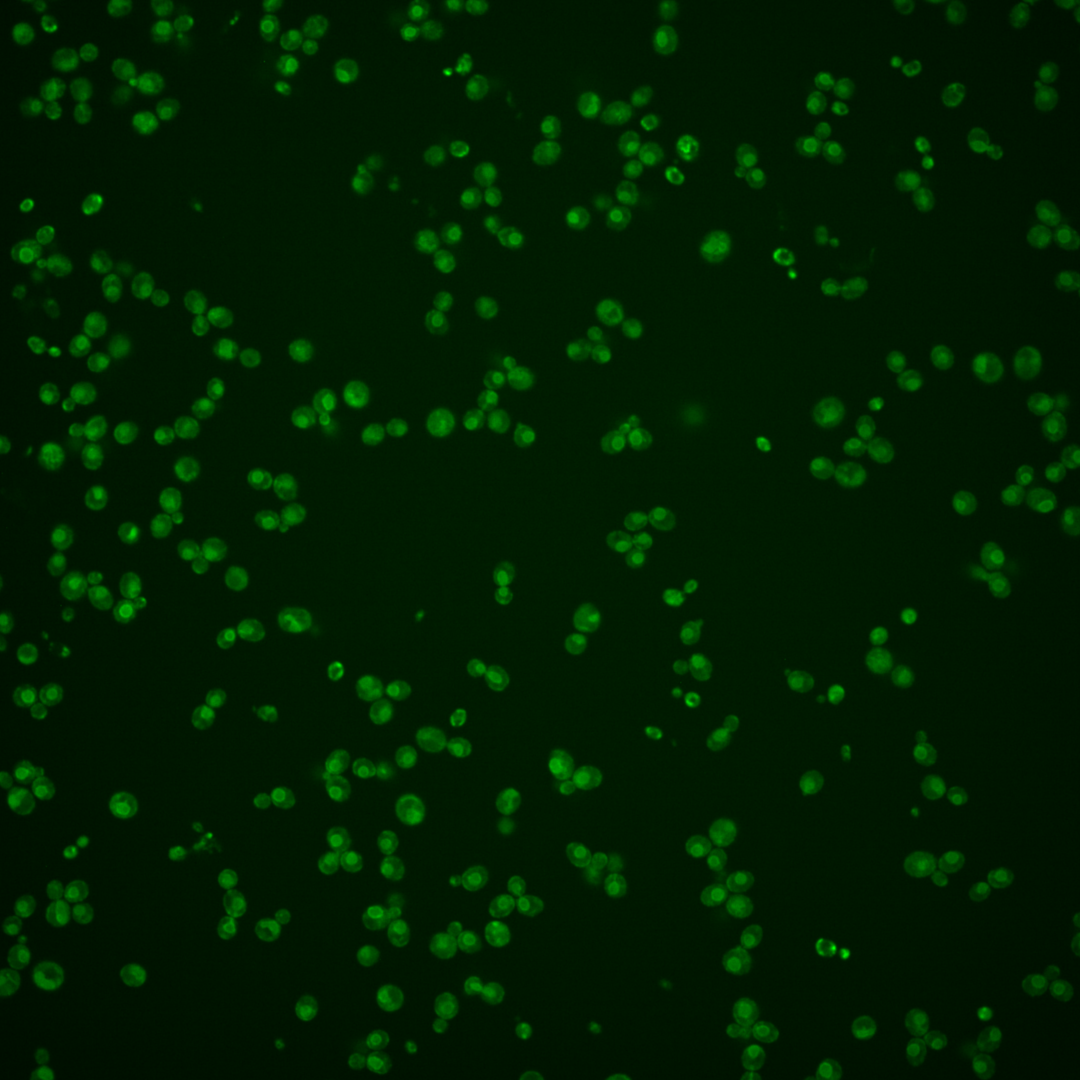
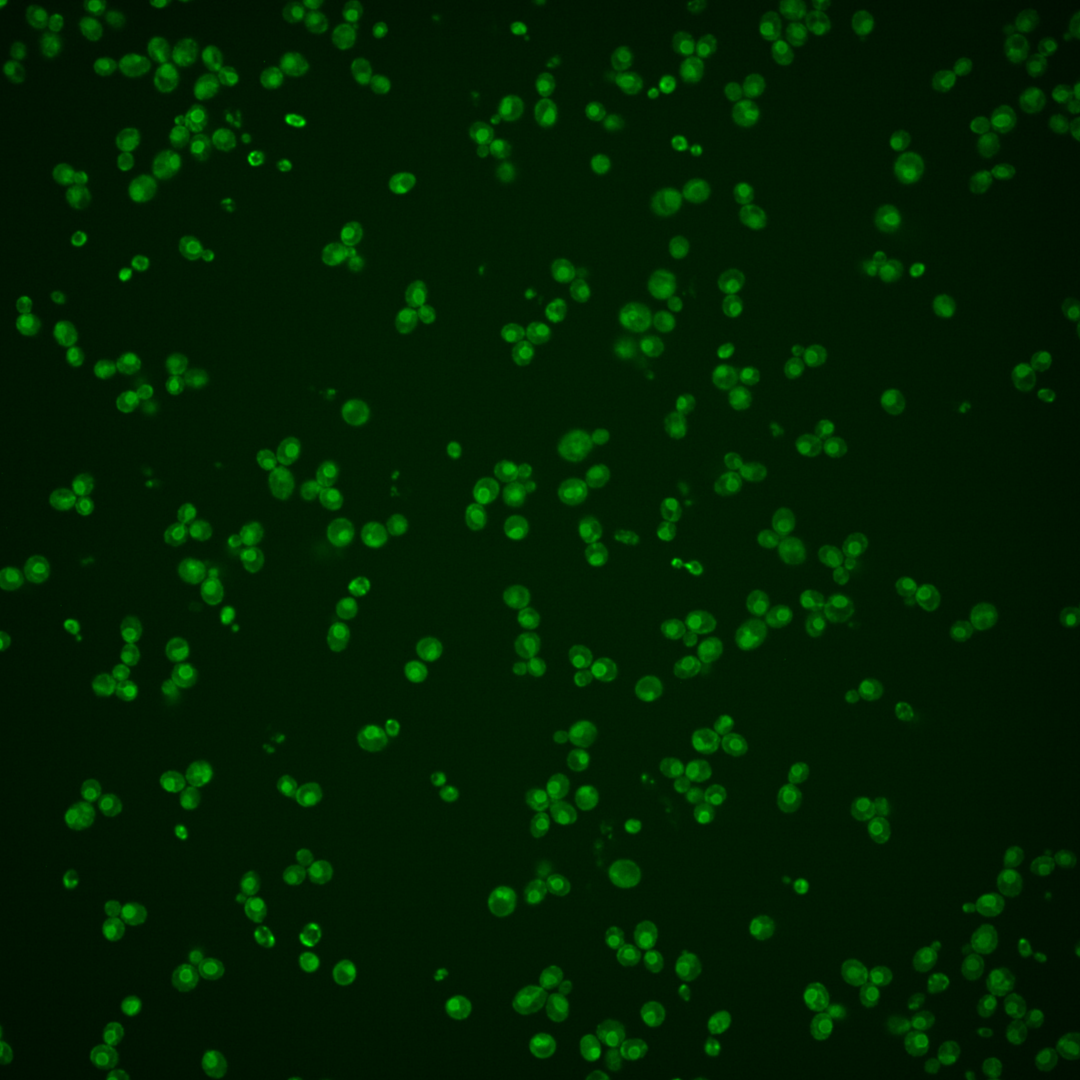

| Standard name | |
|---|---|
| Human Ortholog | |
| Description | Glycerol 3-phosphate/dihydroxyacetone phosphate sn-1 acyltransferase; dual substrate-specific acyltransferase of the glycerolipid biosynthesis pathway; prefers 16-carbon fatty acids; similar to Gpt2p; gene is constitutively transcribed |
Micrographs




















































































Sub-cellular Localization
Yeast GFP Assignment
Protein Abundance
Localization Change
External localization resources
| ensLOC | DeepLoc | |||||||||||||||||||||||
|---|---|---|---|---|---|---|---|---|---|---|---|---|---|---|---|---|---|---|---|---|---|---|---|---|
| Localization | WT1 | WT2 | WT3 | RAP60 | RAP140 | RAP220 | RAP300 | RAP380 | RAP460 | RAP540 | RAP620 | RAP700 | HU80 | HU120 | HU160 | rpd3Δ_1 | rpd3Δ_2 | rpd3Δ_3 | WT1 | WT2 | WT3 | AF100 | AF140 | AF180 |
| Cortical Patches | 10 | 10 | 3 | 8 | 0 | 7 | 2 | 8 | 2 | 4 | 2 | 1 | 3 | 3 | 1 | 11 | 1 | 0 | 7 | 7 | 3 | 4 | 6 | 4 |
| Bud | 0 | 0 | 0 | 0 | 1 | 3 | 1 | 11 | 14 | 9 | 8 | 6 | 1 | 2 | 0 | 1 | 0 | 0 | 2 | 1 | 0 | 0 | 3 | 3 |
| Bud Neck | 0 | 0 | 0 | 0 | 0 | 0 | 0 | 0 | 0 | 0 | 0 | 0 | 0 | 0 | 0 | 0 | 1 | 0 | 0 | 2 | 1 | 0 | 0 | 0 |
| Bud Site | 0 | 0 | 0 | 0 | 0 | 0 | 0 | 0 | 0 | 1 | 0 | 0 | 0 | 0 | 0 | 0 | 0 | 0 | – | – | – | – | – | – |
| Cell Periphery | 10 | 23 | 9 | 15 | 21 | 12 | 15 | 21 | 15 | 23 | 7 | 21 | 5 | 21 | 25 | 41 | 17 | 29 | 1 | 2 | 2 | 1 | 4 | 2 |
| Cytoplasm | 56 | 48 | 37 | 25 | 39 | 69 | 83 | 118 | 70 | 98 | 65 | 73 | 17 | 53 | 48 | 118 | 72 | 49 | 12 | 13 | 2 | 1 | 9 | 9 |
| Endoplasmic Reticulum | 331 | 292 | 154 | 102 | 55 | 136 | 105 | 147 | 63 | 79 | 58 | 75 | 52 | 127 | 68 | 4 | 1 | 0 | 387 | 325 | 243 | 124 | 229 | 203 |
| Endosome | 1 | 0 | 1 | 1 | 11 | 2 | 5 | 9 | 4 | 3 | 2 | 3 | 0 | 0 | 0 | 3 | 1 | 1 | 2 | 2 | 0 | 0 | 1 | 5 |
| Golgi | 4 | 1 | 2 | 1 | 3 | 0 | 1 | 0 | 0 | 0 | 0 | 0 | 0 | 0 | 0 | 2 | 0 | 0 | 2 | 3 | 1 | 0 | 1 | 2 |
| Mitochondria | 4 | 6 | 14 | 26 | 20 | 79 | 120 | 118 | 118 | 175 | 95 | 164 | 0 | 0 | 0 | 27 | 12 | 7 | 5 | 2 | 5 | 7 | 10 | 4 |
| Nucleus | 0 | 1 | 0 | 2 | 2 | 0 | 4 | 8 | 3 | 3 | 2 | 5 | 0 | 4 | 0 | 7 | 4 | 2 | 0 | 1 | 0 | 0 | 0 | 0 |
| Nuclear Periphery | 5 | 7 | 8 | 7 | 3 | 2 | 25 | 22 | 10 | 12 | 11 | 15 | 0 | 1 | 0 | 4 | 2 | 1 | 2 | 0 | 3 | 2 | 0 | 1 |
| Nucleolus | 0 | 0 | 0 | 0 | 0 | 0 | 1 | 2 | 0 | 2 | 0 | 0 | 0 | 0 | 0 | 0 | 0 | 0 | 0 | 0 | 0 | 0 | 0 | 0 |
| Peroxisomes | 0 | 0 | 1 | 0 | 0 | 0 | 0 | 0 | 0 | 0 | 0 | 0 | 0 | 0 | 0 | 0 | 0 | 0 | 0 | 0 | 0 | 0 | 0 | 0 |
| SpindlePole | 1 | 0 | 1 | 0 | 1 | 0 | 0 | 0 | 0 | 0 | 0 | 0 | 0 | 0 | 0 | 2 | 0 | 0 | 0 | 0 | 0 | 0 | 0 | 1 |
| Vac/Vac Membrane | 72 | 15 | 48 | 19 | 110 | 43 | 74 | 130 | 68 | 83 | 23 | 52 | 1 | 13 | 36 | 48 | 14 | 13 | 6 | 11 | 1 | 4 | 17 | 23 |
| Unique Cell Count | 403 | 346 | 232 | 161 | 221 | 280 | 334 | 471 | 277 | 379 | 211 | 328 | 72 | 190 | 153 | 236 | 112 | 95 | 438 | 378 | 271 | 153 | 290 | 264 |
| Labelled Cell Count | 494 | 403 | 278 | 206 | 266 | 353 | 436 | 594 | 367 | 492 | 273 | 415 | 79 | 224 | 178 | 268 | 125 | 102 | 438 | 378 | 271 | 153 | 290 | 264 |
Yeast GFP Assignment
Protein Abundance
| Screen | WT1 | WT2 | WT3 | RAP60 | RAP140 | RAP220 | RAP300 | RAP380 | RAP460 | RAP540 | RAP620 | RAP700 | HU80 | HU120 | HU160 | rpd3Δ_1 | rpd3Δ_2 | rpd3Δ_3 | AF100 | AF140 | AF180 |
|---|---|---|---|---|---|---|---|---|---|---|---|---|---|---|---|---|---|---|---|---|---|
| Mean Cell GFP Intensity (1e-4) | 10.0 | 9.9 | 9.5 | 9.3 | 8.8 | 7.5 | 7.2 | 7.3 | 6.4 | 6.0 | 6.1 | 6.0 | 8.9 | 9.3 | 9.8 | 6.8 | 7.3 | 9.4 | 9.7 | 10.5 | 11.1 |
| Std Deviation (1e-4) | 1.3 | 1.4 | 1.6 | 1.8 | 1.3 | 1.6 | 1.3 | 1.4 | 1.1 | 1.2 | 1.2 | 1.1 | 1.1 | 1.3 | 1.1 | 1.1 | 1.2 | 1.5 | 1.8 | 1.9 | 1.6 |
| Intensity Change (Log2) | – | – | – | -0.03 | -0.11 | -0.33 | -0.39 | -0.38 | -0.57 | -0.66 | -0.63 | -0.67 | -0.09 | -0.03 | 0.05 | -0.48 | -0.37 | -0.02 | 0.03 | 0.15 | 0.23 |
Localization Change
| Localization | RAP60 | RAP140 | RAP220 | RAP300 | RAP380 | RAP460 | RAP540 | RAP620 | RAP700 | HU80 | HU120 | HU160 | rpd3Δ_1 | rpd3Δ_2 | rpd3Δ_3 |
|---|---|---|---|---|---|---|---|---|---|---|---|---|---|---|---|
| Cortical Patches | 0 | 0 | 0 | 0 | 0 | 0 | 0 | 0 | 0 | 0 | 0 | 0 | 2.1 | 0 | 0 |
| Bud | 0 | 0 | 0 | 0 | 0 | 3.5 | 0 | 0 | 0 | 0 | 0 | 0 | 0 | 0 | 0 |
| Bud Neck | 0 | 0 | 0 | 0 | 0 | 0 | 0 | 0 | 0 | 0 | 0 | 0 | 0 | 0 | 0 |
| Bud Site | 0 | 0 | 0 | 0 | 0 | 0 | 0 | 0 | 0 | 0 | 0 | 0 | 0 | 0 | 0 |
| Cell Periphery | 2.2 | 2.4 | 0.2 | 0.4 | 0.4 | 0.8 | 1.2 | -0.3 | 1.3 | 0 | 2.9 | 4.2 | 4.7 | 3.7 | 6.8 |
| Cytoplasm | -0.1 | 0.5 | 2.4 | 2.5 | 2.7 | 2.6 | 2.9 | 3.7 | 1.9 | 1.5 | 3.0 | 3.6 | 7.8 | 9.0 | 6.6 |
| Endoplasmic Reticulum | -0.6 | -8.9 | -4.0 | -8.2 | -8.9 | -9.9 | -11.2 | -8.2 | -10.3 | 0.9 | 0.1 | -4.3 | -14.8 | -11.4 | -10.9 |
| Endosome | 0 | 3.0 | 0 | 0 | 0 | 0 | 0 | 0 | 0 | 0 | 0 | 0 | 0 | 0 | 0 |
| Golgi | 0 | 0 | 0 | 0 | 0 | 0 | 0 | 0 | 0 | 0 | 0 | 0 | 0 | 0 | 0 |
| Mitochondria | 3.3 | 1.2 | 6.5 | 8.2 | 6.1 | 9.4 | 10.4 | 9.5 | 11.0 | 0 | -3.4 | -3.1 | 2.1 | 1.5 | 0.4 |
| Nucleus | 0 | 0 | 0 | 0 | 0 | 0 | 0 | 0 | 0 | 0 | 0 | 0 | 0 | 0 | 0 |
| Nuclear Periphery | 0.5 | -1.4 | 0 | 2.0 | 0.8 | 0.1 | -0.2 | 0.9 | 0.7 | 0 | 0 | 0 | -1.2 | 0 | 0 |
| Nucleolus | 0 | 0 | 0 | 0 | 0 | 0 | 0 | 0 | 0 | 0 | 0 | 0 | 0 | 0 | 0 |
| Peroxisomes | 0 | 0 | 0 | 0 | 0 | 0 | 0 | 0 | 0 | 0 | 0 | 0 | 0 | 0 | 0 |
| SpindlePole | 0 | 0 | 0 | 0 | 0 | 0 | 0 | 0 | 0 | 0 | 0 | 0 | 0 | 0 | 0 |
| Vacuole | -2.3 | 6.5 | -1.6 | 0.4 | 2.0 | 1.0 | 0.4 | -2.8 | -1.5 | -3.9 | -4.0 | 0.7 | -0.1 | -1.9 | -1.5 |
External localization resources
Images






























Protein Concentration and Protein Localization Data
| R1 | R2 | R3 | ||||||||||||||||
|---|---|---|---|---|---|---|---|---|---|---|---|---|---|---|---|---|---|---|
| G1 Pre-START | G1 Post-START | S/G2 | Metaphase | Anaphase | Telophase | G1 Pre-START | G1 Post-START | S/G2 | Metaphase | Anaphase | Telophase | G1 Pre-START | G1 Post-START | S/G2 | Metaphase | Anaphase | Telophase | |
| Concentration | 5.2079 | 6.7937 | 5.9404 | 6.1399 | 4.7619 | 6.0444 | 7.6309 | 8.0919 | 8.1642 | 7.652 | 8.3362 | 8.117 | 9.6736 | 9.4933 | 9.2179 | 9.1888 | 8.8494 | 9.1423 |
| Actin | 0.0362 | 0.0002 | 0.0118 | 0.0007 | 0.0204 | 0.0055 | 0.0403 | 0.0168 | 0.0009 | 0.0003 | 0.0002 | 0.0006 | 0.0012 | 0.0003 | 0.0001 | 0.0005 | 0.0002 | 0.0001 |
| Bud | 0.0002 | 0 | 0.0003 | 0 | 0.0001 | 0 | 0.0001 | 0.0001 | 0 | 0 | 0 | 0 | 0 | 0 | 0 | 0 | 0 | 0 |
| Bud Neck | 0.0004 | 0.0002 | 0.0044 | 0.0003 | 0.0008 | 0.0005 | 0.0006 | 0.0004 | 0.0001 | 0.0002 | 0.0003 | 0.0066 | 0 | 0.0001 | 0 | 0.0025 | 0.0002 | 0.0002 |
| Bud Periphery | 0.0005 | 0 | 0.0004 | 0 | 0.0002 | 0.0001 | 0.0003 | 0.0001 | 0 | 0 | 0 | 0.0001 | 0 | 0 | 0 | 0.0001 | 0 | 0 |
| Bud Site | 0.0007 | 0.0001 | 0.0024 | 0.0001 | 0.0001 | 0 | 0.0001 | 0.002 | 0.0002 | 0 | 0 | 0 | 0.0001 | 0.0002 | 0 | 0.0001 | 0 | 0 |
| Cell Periphery | 0.0008 | 0.002 | 0.0014 | 0.0003 | 0.001 | 0.0003 | 0.0008 | 0.0018 | 0.0007 | 0.0014 | 0.0004 | 0.0006 | 0.0004 | 0.0007 | 0.0011 | 0.0013 | 0.0006 | 0.0004 |
| Cytoplasm | 0.0296 | 0.0695 | 0.0511 | 0.0505 | 0.0363 | 0.0309 | 0.0038 | 0.065 | 0.0177 | 0.0347 | 0.0466 | 0.0271 | 0.0159 | 0.027 | 0.0135 | 0.0306 | 0.0339 | 0.0159 |
| Cytoplasmic Foci | 0.0098 | 0.0007 | 0.0051 | 0.0007 | 0.0084 | 0.0007 | 0.001 | 0.0051 | 0.0042 | 0.0024 | 0.0009 | 0.0005 | 0.001 | 0.0011 | 0.0006 | 0.0006 | 0.0008 | 0.0002 |
| Eisosomes | 0.0007 | 0 | 0.0001 | 0 | 0.0001 | 0 | 0.0006 | 0.0002 | 0 | 0 | 0 | 0.0001 | 0 | 0 | 0 | 0 | 0 | 0 |
| Endoplasmic Reticulum | 0.8143 | 0.896 | 0.8758 | 0.8976 | 0.8231 | 0.9315 | 0.8877 | 0.884 | 0.9469 | 0.9312 | 0.9378 | 0.9415 | 0.9665 | 0.9433 | 0.9742 | 0.9582 | 0.9408 | 0.9764 |
| Endosome | 0.0189 | 0.0025 | 0.0097 | 0.0045 | 0.035 | 0.0043 | 0.0069 | 0.0037 | 0.011 | 0.0133 | 0.002 | 0.0037 | 0.0012 | 0.0048 | 0.0024 | 0.001 | 0.0057 | 0.0009 |
| Golgi | 0.0051 | 0.0004 | 0.0037 | 0.0002 | 0.0172 | 0.0012 | 0.009 | 0.0056 | 0.007 | 0.001 | 0.0003 | 0.0003 | 0.0007 | 0.0005 | 0.0003 | 0.0003 | 0.0009 | 0.0001 |
| Lipid Particles | 0.017 | 0.0069 | 0.0071 | 0.0006 | 0.0075 | 0.0032 | 0.0234 | 0.0073 | 0.0041 | 0.0061 | 0.0016 | 0.0007 | 0.0016 | 0.0098 | 0.0017 | 0.0007 | 0.0045 | 0.0005 |
| Mitochondria | 0.0052 | 0.0001 | 0.0018 | 0.0002 | 0.0081 | 0.0028 | 0.0012 | 0.0002 | 0.0002 | 0.0001 | 0.0001 | 0.0001 | 0 | 0.0001 | 0 | 0 | 0.0001 | 0 |
| None | 0.0121 | 0.0002 | 0.0039 | 0.0019 | 0.0009 | 0.0002 | 0.0004 | 0.0004 | 0.0001 | 0.0003 | 0.0034 | 0.002 | 0.0004 | 0.0003 | 0.0003 | 0.0002 | 0.0068 | 0.0003 |
| Nuclear Periphery | 0.0339 | 0.015 | 0.0097 | 0.0203 | 0.0191 | 0.0123 | 0.0178 | 0.0047 | 0.0045 | 0.0055 | 0.0043 | 0.0113 | 0.009 | 0.0079 | 0.0035 | 0.0023 | 0.0031 | 0.0033 |
| Nucleolus | 0.0001 | 0 | 0.0004 | 0.0004 | 0.0001 | 0.0004 | 0.0001 | 0 | 0 | 0 | 0 | 0.0001 | 0 | 0 | 0 | 0 | 0 | 0 |
| Nucleus | 0.0027 | 0.0009 | 0.0027 | 0.0151 | 0.0011 | 0.0026 | 0.0006 | 0.0003 | 0.0002 | 0.0003 | 0.0004 | 0.0014 | 0.0005 | 0.0009 | 0.0002 | 0.0002 | 0.0002 | 0.0004 |
| Peroxisomes | 0.0052 | 0 | 0.0032 | 0 | 0.0089 | 0.0002 | 0.0011 | 0.0002 | 0.0001 | 0 | 0 | 0 | 0 | 0 | 0 | 0 | 0 | 0 |
| Punctate Nuclear | 0.0024 | 0.0001 | 0.0015 | 0.0044 | 0.0009 | 0.0005 | 0.0004 | 0.0003 | 0.0001 | 0.0001 | 0.0001 | 0.0003 | 0 | 0.0003 | 0 | 0 | 0.0001 | 0 |
| Vacuole | 0.003 | 0.0046 | 0.003 | 0.0018 | 0.0058 | 0.002 | 0.0026 | 0.0015 | 0.0017 | 0.0027 | 0.0015 | 0.0025 | 0.0011 | 0.0026 | 0.0019 | 0.0013 | 0.0018 | 0.0013 |
| Vacuole Periphery | 0.0013 | 0.0004 | 0.0005 | 0.0004 | 0.0048 | 0.0006 | 0.0012 | 0.0001 | 0.0002 | 0.0002 | 0.0001 | 0.0003 | 0.0002 | 0.0002 | 0.0001 | 0.0001 | 0.0002 | 0.0001 |
Sequencing Data
| R1 | R2 | |||||||||
|---|---|---|---|---|---|---|---|---|---|---|
| G1 Post-START | S/G2 | Metaphase | Anaphase | Telophase | G1 Post-START | S/G2 | Metaphase | Anaphase | Telophase | |
| Gene Expression | 46.4591 | 44.9926 | 47.8325 | 45.109 | 46.7459 | 54.656 | 51.6159 | 48.7131 | 47.1571 | 45.412 |
| Translational Efficiency | 0.4288 | 0.4357 | 0.3524 | 0.4036 | 0.3738 | 0.3381 | 0.3364 | 0.3953 | 0.3992 | 0.3761 |
Hit Data
| Dataset | Hit |
|---|---|
| Protein Concentration | ✘ |
| Protein Localization | ✘ |
| Gene Expression | ✘ |
| Translational Efficiency | ✘ |
Endocytosis
| Temp | Actin Patch (Sac6-tdTomato) | Cortical Patch (Sla1-GFP) | Late Endosome (Snf7-GFP) | Vacuole (Vph1-GFP) |
|---|---|---|---|---|
| 37℃ | ||||
| RT |
Cell Cycle Omics
CYCLoPs (Sct1-GFP)
| Gene / Allele | Actin Patch (Sac6-tdTomato) | Cortical Patch (Sla1-GFP) | Late Endosome (Snf7-GFP) | Vacuole (Sac6-tdTomato) |
|---|
| Gene | Images |
|---|
| Gene | Images |
|---|
Images are not yet available
Images are not yet available